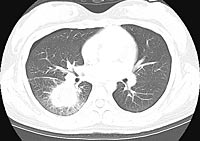

OUR ANSWERS:
Chest
X-ray:
1. Under exposure film
2. Increasing consolidation
3. There is a question of an added density by breast shadow. There is
a mass like opacity but with no cavitation
DIFFERENTIAL DIAGNOSIS:
–
Fungal
infection
–
Viral
infection
–
T.B.
–
Necrotizing
pneumonia
–
Lung
abscess
–
Metastatic
lung cancer
A CT SCAN was done and selected cuts are seen
below.
ENLARGE
this CT image.
ENLARGE
this CT image.
 ENLARGE
this CT image.
ENLARGE
this CT image.
WHAT IS YOUR INTERPRETATION?
